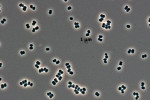
onionSearch

The FBI has launched an investigation into Signal chat groups allegedly used to impede and obstruct federal immigration authorities, Director Kash Patel reveale...
Oscar-Shortlisted 'All the Empty Rooms,' directed by Joshua Seftel, memorializes children killed in school shootings.
After a user’s age has been verified, they’ll be able to chat with others in similar age groups.
People affected by AI-induced delusions, or “spiraling,” from intense chatbot interactions are finding help and community online.
The BBC has confirmed 'The Claudia Winkleman Show', a talk show hosted by the 'Traitors' and former 'Strictly Come Dancing' presenter.
Before WhatsApp and Telegram, before Twitter and Facebook, AOL Instant Messenger was the place the internet gathered to talk to each other. This is its story.
Les parlementaires en Lituanie ont pris une décision bien étrange… Ils ont voté pour qu'un chat ait son mot à dire dans une décision polémique.
En un clic ou quelques messages, l’engrenage d’une arnaque est très vite enclenché. Dans le quatrième épisode de notre série, Albert a vu des milliers ...
Devenu la coqueluche de la gare de Jette, Grijsje accumule les avis élogieux sur Google Maps et attire la sympathie des usagers du quartier.
18 years ago, a sneaky bacteria infiltrated some of the cleanest places on Earth. Scientists finally know how.
The Pentagon watchdog recently completed its report on Defense Secretary Pete Hegseth's use of Signal to share details about operations in Yemen.
Les arguments visant à promouvoir le recours à l'IA générative au sein de la justice sont connus. Mais ce narratif masque mal le fait que son usage pose...
Comment accompagner chiens et chats dans leur vieillissement ? Les conseils pratiques de spécialistes en sciences vétérinaires (alimentation, aménagement, ...
Roblox is rolling out facial age checks and new chat limits to keep adult conversations separated from kids on its platform.
Defense contractor Govini said Gillespie was no longer a majority shareholder and would not receive a paycheck since his termination.
Chat is X’s new DM replacement, with end-to-end encryption, video calls, and disappearing messages.
Meta is rolling out support for third-party messaging with end-to-end encryption preserved. BirdyChat and Haiket will be first.
Apartment rentals firm Sonder said it's liquidating operations, a day after Marriott said a licensing agreement between the two companies had ended.
Stranger Things’ Millie Bobby Brown, Noah Schnapp and Caleb McLaughlin shared what goes on in the Hawkins’ kids group chat and who from the cast keeps it t...
Baseball legend Alex Rodriguez opened up about his journey with mental health and therapy, acknowledging how far things have come in sports